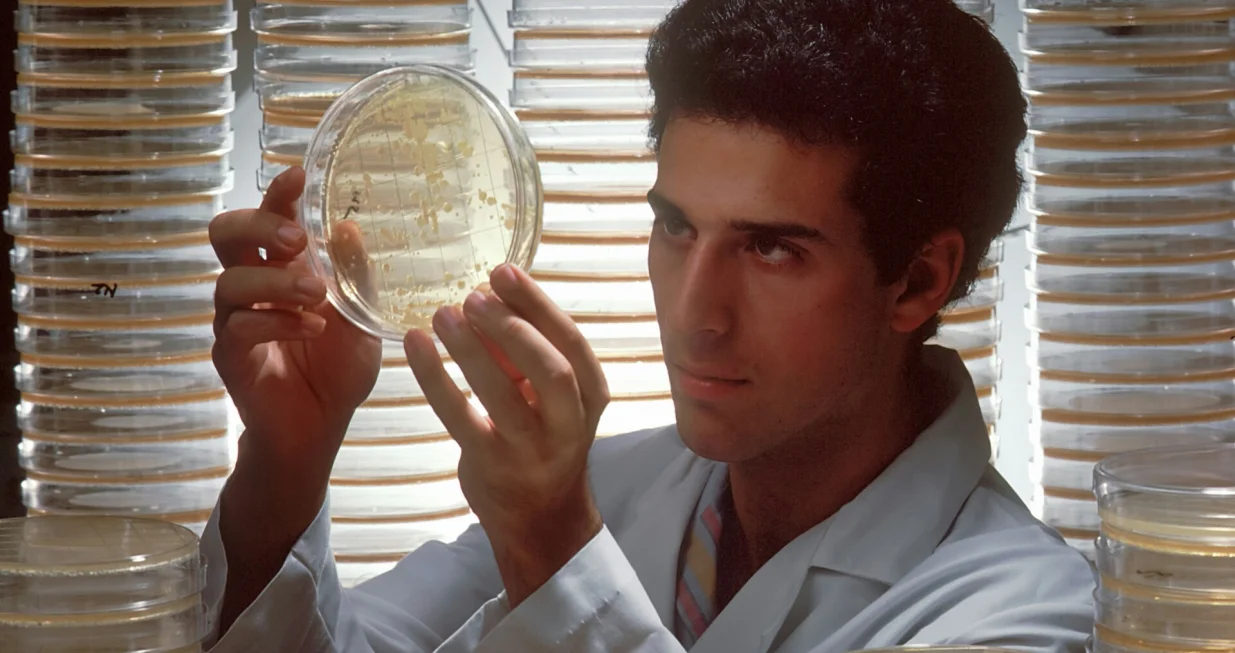
biolog, naučnik, doktor, istraživač, hemičar/National Cancer Institute

Milijarder predviđa da će samo tri posla preživjeti preuzimanje od strane AI: Evo zašto
Umjetna inteligencija više nije samo futuristička priča – ona se upravo sada razvija i nevjerovatnom brzinom mijenja industrije širom svijeta. Dok jedni u AI vide najveću tehnološku revoluciju našeg doba, drugi strahuju od talasa masovnog gubitka radnih mjesta koji bi mogao uslijediti. Prema riječima Billa Gatesa, jednog od najpoznatijih ljudi u svijetu tehnologije, ti strahovi nisu bez osnova.
Gates otvoreno upozorava da će vještačka inteligencija u narednim godinama „ugasiti“ mnoga radna mjesta, automatizirajući poslove u raznim sektorima. Ipak, u moru neizvjesnosti, Gates vidi i zanimljivu iznimku: tri profesije za koje vjeruje da ih AI još dugo neće moći potpuno zamijeniti.
Programeri: Oni koji grade AI
Ironija je u tome što su upravo ljudi koji razvijaju AI među onima čiji će se posao najduže zadržati. Iako je AI već sposoban da piše jednostavne dijelove koda, Gates smatra da i dalje nema preciznost i rješavanje složenih problema koje donosi ljudski mozak. Programeri ostaju ključni za otklanjanje grešaka, nadogradnju i usavršavanje samih AI sistema – AI, jednostavno, treba ljude da ga održavaju na životu.
Energetski stručnjaci: Čuvari snage
Sektor energije previše je složen da bi ga AI samostalno vodio. Bilo da je riječ o nafti, nuklearnoj energiji ili obnovljivim izvorima, potrebni su stručnjaci koji razumiju propise, planiraju strategije održivosti i reagiraju u kriznim situacijama. Gates tvrdi da AI može pomoći u analizi, ali ljudska prosudba i iskustvo ostaju nezamjenjivi.
Biolozi: Istraživači života
Biolozi, posebno oni koji rade na medicinskim istraživanjima, koriste kreativnost, intuiciju i kritičko razmišljanje – osobine koje AI još uvijek ne može oponašati. Dok AI može analizirati ogromne baze podataka ili pomoći u dijagnostici, ne može formulirati revolucionarne hipoteze ili donijeti instinktivne zaključke koji mijenjaju pravila igre.
Šta nas čeka?
Gates priznaje da su i ove procjene podložne promjenama, jer se AI razvija neviđenom brzinom. Baš kao što su industrijska revolucija i internet preokrenuli svijet rada, AI će definirati koje vještine ostaju dragocjene. Za sada, programeri, energetski stručnjaci i biolozi mogu odahnuti, ali svi ostali bi možda trebali razmisliti o novim vještinama i prilagodbi vremenu koje dolazi.
Govoreći nedavno na televiziji, Gates je ponovio da bi AI za samo deset godina mogao doći do tačke gdje ljudska stručnost više neće biti nužna za većinu poslova. Iako je optimističan kada je riječ o potencijalu AI-ja da unaprijedi obrazovanje i medicinu, upozorava na opasnosti od dezinformacija, pristrasnosti i zloupotrebe tehnologije.
Na kraju, Gates poručuje mladim ljudima da ne bježe od AI-ja, već da je iskoriste kao priliku. Budućnost neće zavisiti samo o tome šta AI može – već i o tome kako ćemo se mi kao ljudi znati prilagoditi i razvijati uz njega.




















